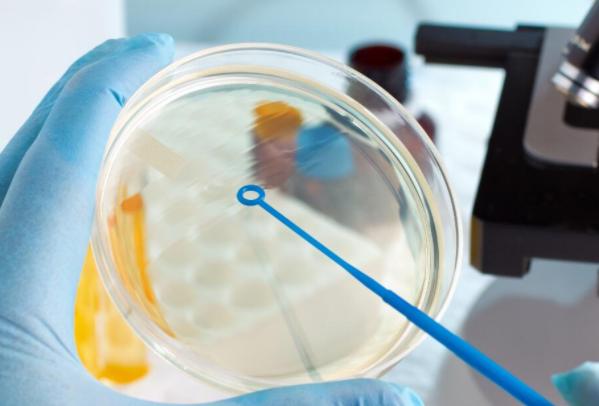
美国试管婴儿的费用和成本分析,你不容错过的攻略

更新时间:2023-11-20
试管婴儿是一种较为复杂的生育技术,需要花费大量的时间和金钱。美国作为试管婴儿技术比较发达的国家之一,其费用也是相当昂贵的。本文将为您介绍美国试管婴儿的相关费用和注意事项。
我们需要了解美国试管婴儿的基本价格。根据统计数据显示,平均来说,试管婴儿在美国的总费用约为2.5万到4.5万美元不等。这个价格助孕括了许多方面的花费,例如医疗检查、药品治疗、手术操作、胚胎移植等等。
其中比较大的开销是药物治疗。因为在进行人工受孕前需要使用荷尔蒙类药物来促进卵泡发育和排卵,这些药物价格相当昂贵,在整个治疗过程中占据了很大比例。
除此之外,还有一些额外费用需要考虑。例如助孕冷冻胚胎或三代试管生子、进行遗传学检查和胎儿筛查等。这些费用可能会增加总费用,具体价格取决于医院和诊所的收费标准。
需要注意的是,虽然试管婴儿在美国的总花费相对较高,但在不同地区和诊所之间也有很大差异。因此在选择医院和诊所时,一定要认真比较,并选出符合自己经济能力的。
除了费用问题外,令人关注的还有试管婴儿的成功率。虽然技术越来越先进,但每个人都存在不同的生理差异,因此成功率也会存在一定程度上的变化。
根据统计数据显示,整个过程中受孕成功率约为30%至40%,而且受孕之后还有一定概率发生流产或其他并发症。因此在进行试管婴儿前一定要了解自己的身体情况,并做好心理准备。
试管婴儿是一项昂贵且复杂的生育技术,在美国进行更是需要考虑到各种方面的花费。除了基本医疗费用外,还有药物治疗、遗传学检查等其他费用需要考虑。同时成功率也存在一定程度上的不确定性。因此在选择进行试管婴儿时一定要认真思考,并做好相应的准备。
以上就是医院招聘网小编为大家整理的《美国试管婴儿的费用和成本分析,你不容错过的攻略》相关信息,希望大家喜欢。
内容版权声明:本网站部分内容由网上整理转发,如有侵权请联系管理员进行删除.